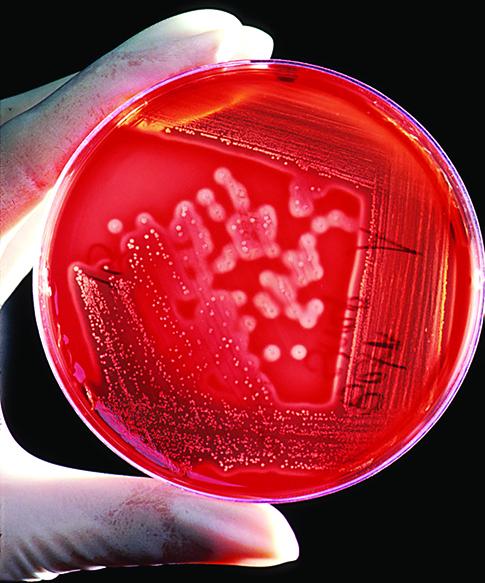
A photo shows a gloved hand holding a petri dish with circular bacteria colonies growing in the growth medium.

Learning Objectives
Learning Objectives
In this section, you will explore the following question:
- What is the overall result, in terms of molecules produced, in the breakdown of glucose by glycolysis?
Connection for AP® Courses
Connection for AP® Courses
All organisms, from simple bacteria and yeast to complex plants and animals, carry out some form of cellular respiration to capture and supply free energy for cellular processes. Although cellular respiration and photosynthesis evolved as independent processes, today they are interdependent. The products of photosynthesis, carbohydrates, and oxygen gas, are used during cellular respiration. Likewise, the byproduct of cellular respiration, CO2 gas, is used during photosynthesis. Glycolysis is the first pathway used in the breakdown of glucose to extract free energy. Used by nearly all organisms on Earth today, glycolysis likely evolved as one of the first metabolic pathways. It is important to note that glycolysis occurs in the cytoplasm of both prokaryotic and eukaryotic cells. Remember that only eukaryotic cells have mitochondria.
Like all metabolic pathways, glycolysis occurs in steps or stages. In the first stage, the six-carbon ring of glucose is prepared for cleavage, or splitting, into two three-carbon molecules by investing two molecules of ATP to energize the separation. As glucose is metabolized further, bonds are rearranged through a series of enzyme-catalyzed steps, and free energy is released to form ATP from ADP and free phosphate molecules. The availability of enzymes can affect the rate of glucose metabolism. Two molecules of pyruvate are ultimately produced. High-energy electrons and hydrogen atoms pass to NAD+, reducing it to NADH. Although two molecules of ATP were invested to destabilize glucose at the beginning of the process, four molecules of ATP are formed by substrate-level phosphorylation, resulting in a net gain of two ATP and two NADH molecules for the cell.
Information presented and the examples highlighted in the section support concepts and Learning Objectives outlined in Big Idea 1 and Big Idea 2 of the AP® Biology Curriculum Framework, as shown in the table. The Learning Objectives listed in the Curriculum Framework provide a transparent foundation for the AP® Biology course, an inquiry-based laboratory experience, instructional activities, and AP® exam questions. A Learning Objective merges required content with one or more of the seven Science Practices.
| Big Idea 1 | The process of evolution drives the diversity and unity of life. |
| Enduring Understanding 1.B | Organisms are linked by lines of descent from common ancestry. |
| Essential Knowledge | 1.B.1 Organisms share many conserved core processes and features that evolved and are widely distributed among organisms today. |
| Science Practice | 7.2 The student can connect concepts in and across domain(s) to generalize or extrapolate in and/or across enduring understandings and/or big ideas. |
| Learning Objective | 1.15 The student is able to describe specific examples of conserved core biological processes and features shared by all domains or within one domain of life, and how these shared, conserved core processes and features support the concept of common ancestry for all organisms. |
| Big Idea 2 | Biological systems utilize free energy and molecular building blocks to grow, to reproduce, and to maintain dynamic homeostasis. |
| Enduring Understanding 2.A | Growth, reproduction, and maintenance of living systems require free energy and matter. |
| Essential Knowledge | 2.A.2 Organisms capture and store free energy for use in biological processes. |
| Science Practice | 1.4 The student can use representations and models to analyze situations or solve problems qualitatively and quantitatively. |
| Science Practice | 3.1 The student can pose scientific questions. |
| Learning Objective | 2.4 The student is able to use representations to pose scientific questions about what mechanisms and structural features allow organisms to capture, store, and use free energy. |
| Essential Knowledge | 2.A.2 Organisms capture and store free energy for use in biological processes. |
| Science Practice | 6.2 The student can construct explanations of phenomena based on evidence produced through scientific practices. |
| Learning Objective | 2.5 The student is able to construct explanations of the mechanisms and structural features of cells that allow organisms to capture, store, or use free energy. |
You have read that nearly all of the energy used by living cells comes to them in the bonds of the sugar, glucose. Glycolysis is the first step in the breakdown of glucose to extract energy for cellular metabolism. Nearly all living organisms carry out glycolysis as part of their metabolism. The process does not use oxygen and is therefore anaerobic. Glycolysis takes place in the cytoplasm of both prokaryotic and eukaryotic cells. Glucose enters heterotrophic cells in two ways. One method is through secondary active transport in which the transport takes place against the glucose concentration gradient. The other mechanism uses a group of integral proteins called GLUT proteins, also known as glucose transporter proteins. These transporters assist in the facilitated diffusion of glucose.
Glycolysis begins with the six carbon ring-shaped structure of a single glucose molecule and ends with two molecules of a three-carbon sugar called pyruvate. Glycolysis consists of two distinct phases. The first part of the glycolysis pathway traps the glucose molecule in the cell and uses energy to modify it so that the six-carbon sugar molecule can be split evenly into the two three-carbon molecules. The second part of glycolysis extracts energy from the molecules and stores it in the form of ATP and NADH, the reduced form of NAD+.
First Half of Glycolysis—Energy-requiring Steps
First Half of Glycolysis—Energy-requiring Steps
Step 1. The first step in glycolysis (Figure 7.6) is catalyzed by hexokinase, an enzyme with broad specificity that catalyzes the phosphorylation of six-carbon sugars. Hexokinase phosphorylates glucose using ATP as the source of the phosphate, producing glucose-6-phosphate, a more reactive form of glucose. This reaction prevents the phosphorylated glucose molecule from continuing to interact with the GLUT proteins, and it can no longer leave the cell because the negatively charged phosphate will not allow it to cross the hydrophobic interior of the plasma membrane.
Step 2. In the second step of glycolysis, an isomerase converts glucose-6-phosphate into one of its isomers, fructose-6-phosphate. An isomerase is an enzyme that catalyzes the conversion of a molecule into one of its isomers. This change from phosphoglucose to phosphofructose allows the eventual split of the sugar into two three-carbon molecules.
Step 3. The third step is the phosphorylation of fructose-6-phosphate, catalyzed by the enzyme phosphofructokinase. A second ATP molecule donates a high-energy phosphate to fructose-6-phosphate, producing fructose-1,6-bisphosphate. In this pathway, phosphofructokinase is a rate-limiting enzyme. It is active when the concentration of ADP is high; it is less active when ADP levels are low and the concentration of ATP is high. Thus, if there is sufficient ATP in the system, the pathway slows down. This is a type of end product inhibition, since ATP is the end product of glucose catabolism.
Step 4. The newly added high-energy phosphates further destabilize fructose-1,6-bisphosphate. The fourth step in glycolysis employs an enzyme, aldolase, to cleave 1,6-bisphosphate into two three-carbon isomers: dihydroxyacetone-phosphate and glyceraldehyde-3-phosphate.
Step 5. An isomerase transforms the dihydroxyacetone-phosphate into its isomer, glyceraldehyde-3-phosphate. Thus, the pathway will continue with two molecules of a single isomer. At this point in the pathway, there is a net investment of energy from two ATP molecules in the breakdown of one glucose molecule.
Second Half of Glycolysis—Energy-Releasing Steps
Second Half of Glycolysis—Energy-Releasing Steps
So far, glycolysis has cost the cell two ATP molecules and produced two small, three-carbon sugar molecules. Both of these molecules will proceed through the second half of the pathway, and sufficient energy will be extracted to pay back the two ATP molecules used as an initial investment and produce a profit for the cell of two additional ATP molecules and two even higher-energy NADH molecules.
Step 6. The sixth step in glycolysis (Figure 7.7) oxidizes the sugar (glyceraldehyde-3-phosphate), extracting high-energy electrons, which are picked up by the electron carrier NAD+, producing NADH. The sugar is then phosphorylated by the addition of a second phosphate group, producing 1,3-bisphosphoglycerate. Note that the second phosphate group does not require another ATP molecule.
Here again is a potential limiting factor for this pathway. The continuation of the reaction depends upon the availability of the oxidized form of the electron carrier, NAD+. Thus, NADH must be continuously oxidized back into NAD+ in order to keep this step going. If NAD+ is not available, the second half of glycolysis slows down or stops. If oxygen is available in the system, the NADH will be oxidized readily, though indirectly, and the high-energy electrons from the hydrogen released in this process will be used to produce ATP. In an environment without oxygen, an alternate pathway, fermentation, can provide the oxidation of NADH to NAD+.
Step 7. In this step, catalyzed by phosphoglycerate kinase—an enzyme named for the reverse reaction—1,3-bisphosphoglycerate donates a high-energy phosphate to ADP, forming one molecule of ATP. This is an example of substrate-level phosphorylation. A carbonyl group on the 1,3-bisphosphoglycerate is oxidized to a carboxyl group, and 3-phosphoglycerate is formed.
Step 8. The remaining phosphate group in 3-phosphoglycerate moves from the third carbon to the second carbon, producing 2-phosphoglycerate—an isomer of 3-phosphoglycerate. The enzyme catalyzing this step is a mutase, or isomerase.
Step 9. Enolase catalyzes the ninth step. This enzyme causes 2-phosphoglycerate to lose water from its structure; this is a dehydration reaction, resulting in the formation of a double bond that increases the potential energy in the remaining phosphate bond and produces phosphoenolpyruvate (PEP).
Step 10. The last step in glycolysis is catalyzed by the enzyme pyruvate kinase. The enzyme in this case is named for the reverse reaction of pyruvate’s conversion into PEP, and it results in the production of a second ATP molecule by substrate-level phosphorylation and the compound pyruvic acid (or its salt form, pyruvate). Many enzymes in enzymatic pathways are named for the reverse reactions, since the enzyme can catalyze both forward and reverse reactions; these may have been described initially by the reverse reaction that takes place in vitro, under non-physiological conditions.
Link to Learning
Gain a better understanding of the breakdown of glucose by glycolysis by visiting this site to see the process in action.
What is the general formula for cellular respiration and what roles do oxygen and carbon dioxide play in this process?
- C6H12O6 + O2 → CO2 + H2O + energy, where glucose is oxidized to release carbon dioxide along with energy, and oxygen is the final acceptor of electrons.
- C6H12O6 + CO2 → O2 + H2O + energy, where glucose is reduced to release oxygen and water. This oxygen in turn accepts electrons from the electron transport chain to form water.
- C6H12O6 + O2 + H2O → CO2 + energy, where glucose is reduced to release carbon dioxide with energy. Oxygen works as a reducing agent by donating electrons.
- C6H12O6 + CO2 + H2O → (CH2O)n + H2O + O2, where glucose is oxidized to release pyruvate and water. The oxygen formed acts as the final acceptor of electrons.
Everyday Connection for AP® Courses
Glycolysis occurs in the cytoplasm of nearly every cell. Organisms, from the small, circular colonies of bacteria pictured here to the human holding the petri dish, perform glycolysis using the same ten enzymes. Because of this, it is thought that glycolysis must have evolved in the very earliest forms of life.
- by the phosphorylation of fructose-6-phosphate
- by the oxidation of glyceraldehyde-3-phosphate
- by the formation of 3-phosphoglycerate
- by the formation of phosphoenolpyruvate
Outcomes of Glycolysis
Outcomes of Glycolysis
Glycolysis starts with glucose and ends with two pyruvate molecules, a total of four ATP molecules and two molecules of NADH. Two ATP molecules were used in the first half of the pathway to prepare the six-carbon ring for cleavage, so the cell has a net gain of two ATP molecules and two NADH molecules for its use. If the cell cannot catabolize the pyruvate molecules further, it will harvest only two ATP molecules from one molecule of glucose. Mature mammalian red blood cells are not capable of aerobic respiration—the process in which organisms convert energy in the presence of oxygen—and glycolysis is their sole source of ATP. If glycolysis is interrupted, these cells lose their ability to maintain their sodium-potassium pumps, and eventually, they die.
The last step in glycolysis will not occur if pyruvate kinase, the enzyme that catalyzes the formation of pyruvate, is not available in sufficient quantities. In this situation, the entire glycolysis pathway will proceed, but only two ATP molecules will be made in the second half. Thus, pyruvate kinase is a rate-limiting enzyme for glycolysis.
Science Practice Connection for AP® Courses
Think About It
- Nearly all organisms on Earth carry out some form of glycolysis. How does that fact support or not support the assertion that glycolysis is one of the oldest metabolic pathways? Justify your answer.
- Human red blood cells do not perform aerobic respiration, but they do perform glycolysis. What might happen if glycolysis were blocked in a red blood cell? Could red blood cells tap into other sources of free energy needed for their functions?
Disclaimer
This section may include links to websites that contain links to articles on unrelated topics. See the preface for more information.